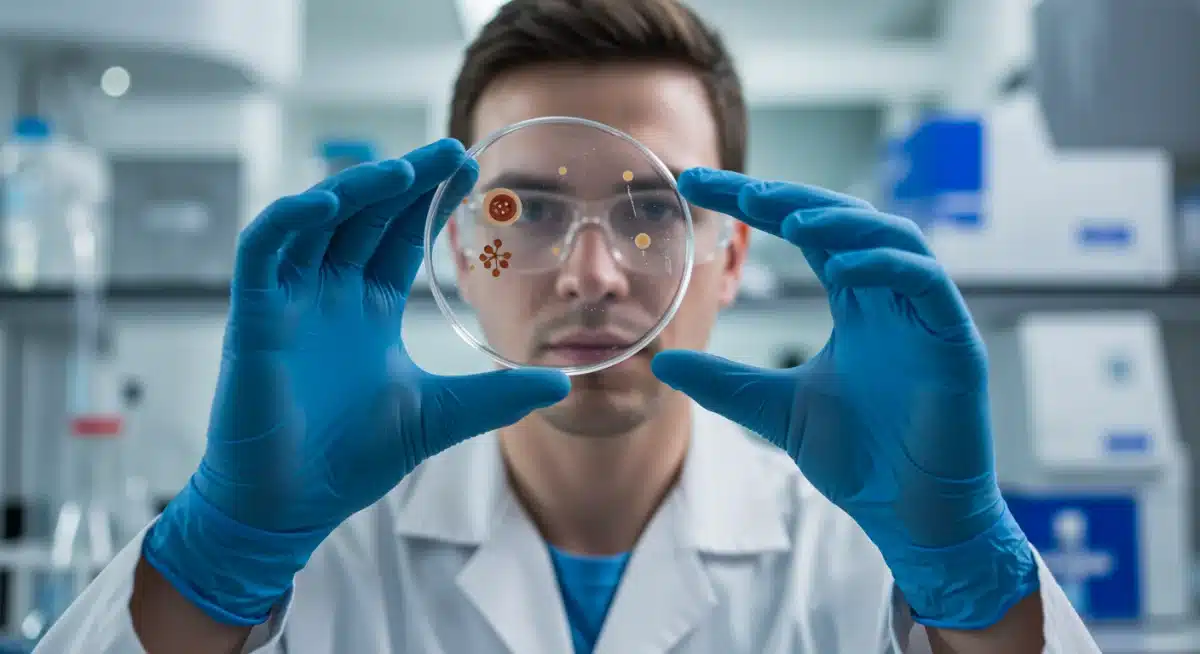
Scientist examining a new medical discovery in a state-of-the-art laboratory

FDA Approves 3 New Medical Breakthroughs for US by Spring 2026
Anúncios
The FDA is set to transform the nation’s clinical landscape with the release of three major Medical Breakthroughs by Spring 2026. These upcoming health solutions represent a pivotal shift in modern medicine, offering renewed hope for patients across the United States.
Industry experts and federal officials have recently unveiled details regarding these high-impact scientific advancements. This wave of therapeutic innovation is expected to significantly improve quality of life while setting a new standard for long-term patient care.
Anúncios
As these pioneering treatments move toward widespread rollout, staying informed on the regulatory timeline is essential. We have broken down the critical updates, exploring why these advancements matter and what you should monitor in the coming months.
Historic FDA Approvals Pave Way for New Era
The recent FDA approvals mark a significant milestone in the ongoing battle against complex diseases. These decisions followed rigorous testing and extensive clinical trials, demonstrating both safety and efficacy across diverse patient populations.
The agency’s thorough review process ensures that only the most promising and well-vetted therapies reach the American public. This commitment to public health underpins the trust placed in these new medical advancements.
Anúncios
The scientific community, patient advocacy groups, and industry leaders are all applauding these approvals, recognizing the immense potential they hold. This collective optimism highlights the collaborative effort required to bring such innovations to fruition.
Understanding the Three Groundbreaking Therapies
The three approved medical breakthroughs address critical unmet needs in distinct therapeutic areas. Each therapy employs novel mechanisms of action, offering solutions where previous treatments fell short or were non-existent.
One of the approved treatments targets a rare neurodegenerative disorder, promising to slow its progression and alleviate debilitating symptoms. This development offers a ray of hope for patients and families who have long faced limited options.
Another breakthrough focuses on a specific type of aggressive cancer, utilizing advanced immunotherapy techniques to re-engage the body’s immune system. The third approval introduces a highly effective gene-editing therapy for a chronic genetic condition, potentially offering a curative approach.
Advancement in Neurodegenerative Disease
This therapy represents a significant leap forward in understanding and treating a condition previously considered untreatable. Early data from clinical trials showed remarkable improvements in patient outcomes, challenging long-held assumptions about the disease’s trajectory.
The treatment works by targeting specific protein aggregates believed to be central to the disease’s pathology. Its precision offers a new pathway for intervention, moving beyond symptomatic relief to address the root causes of the illness.
Immunotherapy for Aggressive Cancer
The FDA’s approval of this cancer immunotherapy underscores the growing power of harnessing the body’s own defenses. This innovative approach has demonstrated impressive response rates in patients who had exhausted other conventional treatments.
The therapy functions by enhancing the immune system’s ability to recognize and destroy cancer cells, minimizing damage to healthy tissues. This nuanced approach offers a more targeted and potentially less toxic alternative to traditional chemotherapy or radiation.
Gene-Editing for Genetic Conditions
The third breakthrough, a gene-editing therapy, signifies a new frontier in personalized medicine, offering the potential for a one-time curative treatment. This technology allows for precise modifications to a patient’s DNA, correcting the genetic defects responsible for the disease.
This approval opens doors for similar gene-editing approaches to be developed for a broader range of genetic disorders. It heralds an era where inherited diseases might be treated not just managed, but fundamentally cured.
Projected Rollout and Accessibility by Spring 2026
The timeline for these therapies to become widely available across the US is set for Spring 2026. This period allows for necessary manufacturing scale-up, distribution logistics, and training for healthcare providers.
Efforts are already underway to ensure equitable access to these life-changing treatments. Collaborations between pharmaceutical companies, healthcare systems, and government agencies aim to address potential barriers to availability.
Patients and healthcare professionals are eagerly anticipating the rollout, understanding the profound impact these options will have. The phased introduction will prioritize patient safety and effective integration into existing medical practices.
Distribution Challenges and Solutions
Distributing complex, often temperature-sensitive, biological therapies across a vast country presents significant logistical hurdles. Specialized cold chain management and secure transportation networks are being established to maintain product integrity.
Manufacturers are expanding production capacities to meet anticipated demand, a crucial step in ensuring broad availability. Supply chain resilience is a key focus, aiming to prevent shortages and ensure consistent access to these vital medications.
Training Healthcare Providers
The introduction of these advanced therapies necessitates comprehensive training for medical staff, including physicians, nurses, and pharmacists.
Educational programs are being developed to familiarize practitioners with administration protocols, patient selection criteria, and potential side effects.
Specialized certifications may be required for healthcare facilities to administer these treatments, ensuring a high standard of care. This investment in professional development is critical for the safe and effective integration of these breakthroughs into clinical practice.
Impact on Patients and Healthcare System
The approval of these three medical breakthroughs is expected to have a profound and lasting impact on patients. For individuals suffering from these specific conditions, the new treatments offer renewed hope for improved health outcomes and a higher quality of life.
Beyond the direct patient benefits, these innovations will also influence the broader healthcare system. They are likely to spur further research and development in related fields, accelerating the pace of medical discovery.
The economic implications, including costs and reimbursement strategies, are also being carefully evaluated. Balancing innovation with affordability remains a key challenge for policymakers and healthcare payers.
Transforming Patient Lives
For patients with neurodegenerative disorders, the new therapy could mean preserving cognitive function and mobility for longer. For cancer patients, it offers a chance at remission and extended survival, previously unattainable.
Individuals with chronic genetic conditions could see their diseases effectively reversed, dramatically altering their life trajectories. These aren’t just treatments; they are opportunities for a healthier, more fulfilling future.
Shaping Future Medical Research
The success of these breakthroughs will undoubtedly inspire new avenues of research in gene therapy, immunotherapy, and targeted drug development. They validate years of scientific effort and investment in cutting-edge biotechnologies.
The FDA’s proactive stance in expediting these approvals also signals a willingness to embrace novel scientific approaches. This encourages further innovation, pushing the boundaries of what is medically possible for future FDA medical breakthroughs approval.
Regulatory Process and Collaboration
The FDA’s decision-making process for these approvals involved extensive collaboration with academic institutions, pharmaceutical companies, and patient advocacy groups. This multi-stakeholder approach is crucial for bringing complex therapies to market efficiently and safely.
The agency utilized expedited review pathways where appropriate, recognizing the urgency of addressing severe unmet medical needs. This commitment to accelerating beneficial therapies without compromising safety standards is a hallmark of the FDA’s mission.
Transparency throughout the regulatory journey has been a priority, keeping the public informed about the progress and rationale behind each approval.
This fosters public trust and confidence in the new treatments as part of the Medical Breakthroughs by Spring 2026.
Expedited Review Pathways
The FDA often employs mechanisms like Breakthrough Therapy designation and Accelerated Approval for therapies that demonstrate substantial improvement over existing treatments for serious conditions.
These pathways streamline the development and review process, bringing critical medicines to patients faster.
Each of the three approved breakthroughs likely benefited from such designations, reflecting their potential to significantly alter disease management. This expedited review does not diminish the rigor of evaluation but rather prioritizes promising candidates.
Stakeholder Engagement
Patient input played a vital role in the approval process, ensuring that the therapies address real-world patient needs and concerns. Advocacy groups provided valuable perspectives on the impact of these diseases and the potential benefits of the new treatments.
Collaboration with pharmaceutical companies ensured that comprehensive data was submitted and thoroughly analyzed.
This partnership between regulators and innovators is essential for navigating the complex journey from laboratory discovery to clinical application for FDA medical breakthroughs approval.
Ethical Considerations and Long-Term Outlook
As with all groundbreaking medical advancements, ethical considerations are paramount. Discussions around equitable access, affordability, and the long-term societal implications of these therapies are already underway, ensuring a responsible rollout.
The long-term outlook for these treatments is overwhelmingly positive, with ongoing research expected to further refine and expand their applications.
Continuous monitoring and post-market surveillance will be crucial for tracking their real-world effectiveness and safety for these FDA medical breakthroughs approval.
These approvals set a precedent for future innovations, demonstrating the power of scientific dedication and regulatory foresight. The coming years will undoubtedly see more such advancements, continuing to redefine the boundaries of medicine.

Ensuring Equitable Access
One of the primary ethical challenges is ensuring that these potentially life-saving treatments are accessible to all who need them, regardless of socioeconomic status. Strategies are being developed to mitigate financial barriers and ensure broad insurance coverage.
Government programs and patient assistance initiatives will likely play a critical role in bridging the gap between high development costs and patient affordability. The goal is to make these FDA medical breakthroughs approval a benefit for all, not just a select few.
Future Research and Development
The scientific journey does not end with approval; it often intensifies. Researchers will continue to explore potential synergistic therapies, investigate broader applications for these treatments, and monitor long-term outcomes to optimize patient care.
The data gathered from the initial rollout will be invaluable for informing subsequent generations of medical innovation. This continuous cycle of research, development, and refinement is what drives progress in modern medicine, especially for the FDA medical breakthroughs approval.
| Key Point | Brief Description |
|---|---|
| FDA Approvals | Three new medical breakthroughs approved for US market. |
| Rollout Timeline | Set to become available across the US by Spring 2026. |
| Therapeutic Areas | Neurodegenerative, aggressive cancer, and genetic conditions. |
| Impact | Transformative for patients, influencing future medical research. |
Frequently Asked Questions About New Medical Breakthroughs
These breakthroughs include a novel treatment for a rare neurodegenerative disorder, an advanced immunotherapy for aggressive cancer, and a pioneering gene-editing therapy for a chronic genetic condition. Each represents a significant advancement over existing treatments, offering new hope and improved outcomes for patients.
The approved therapies are anticipated to roll out across the United States by Spring 2026. This timeline allows for the necessary manufacturing, distribution, and extensive training of healthcare professionals to ensure safe and effective implementation nationwide.
These breakthroughs are expected to revolutionize patient care, potentially reducing long-term healthcare costs associated with chronic disease management. They will also stimulate further research and development, fostering an environment of continuous innovation within the medical community and for future FDA medical breakthroughs approval.
Stakeholders are actively working on strategies to address accessibility and affordability. This includes collaborations with insurance providers, patient assistance programs, and government initiatives to ensure that these life-changing therapies reach all eligible patients, regardless of their financial situation, for the FDA medical breakthroughs approval.
The long-term outlook is highly promising, with expectations for improved patient longevity and quality of life. Ongoing post-market surveillance and additional research will continue to refine their use, potentially expanding their applications and leading to further advancements in targeted medical treatments.
Looking Ahead: The Future of Medicine in the US
The recent Medical Breakthroughs signals a new era for American healthcare. These advancements are not merely isolated events but indicators of a broader trend towards highly targeted and curative therapies.
The emphasis now shifts to effective implementation, ensuring these innovations reach every patient who can benefit from them.
Monitoring the rollout, assessing real-world outcomes, and addressing the ethical and economic implications will be crucial next steps.
The success of these FDA medical breakthroughs approval will undoubtedly pave the way for even more revolutionary treatments, reshaping the landscape of disease management and prevention for generations to come.
This period marks a pivotal moment in medical history, promising a healthier future for millions.





